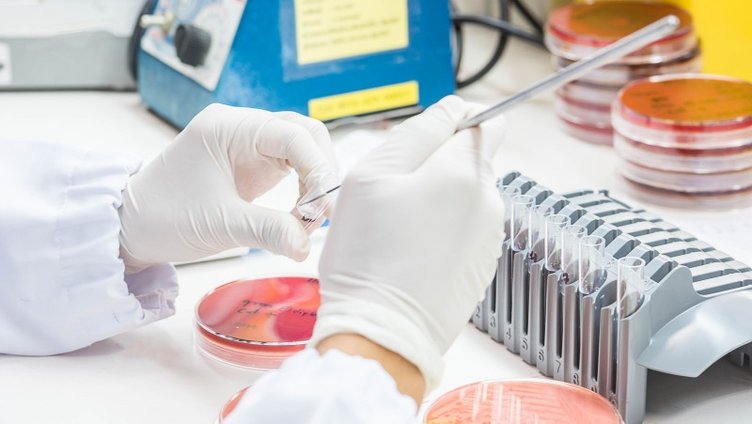
AIDS belirtileri neler? AIDS nasıl bulaşır? AIDS tedavisi var mı?

HIV (İnsan Bağışıklık Yetmezliği Virüsü), doğrudan bağışıklık sistemine zarar veriyor ve bu virüsü taşıyanlar "HIV pozitif" olarak adlandırılıyor. HIV, vücut direncini azaltarak insanların kolayca hasta olmasına neden oluyor.
AIDS (Edinilmiş Bağışıklık Yetersizliği Sendromu) ise HIV virüsünün bağışıklık sistemini zayıflatmasından sonra ortaya çıkan hastalık hali olarak tanımlanıyor.
İşte AIDS'e dair tüm merak edilenler...